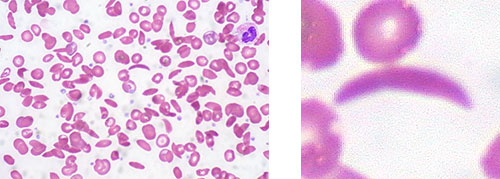

Сборник задач и упражнений по биохимии для студентов медицинских специальностей
Подумайте, какой суммарный заряд будут иметь данные дипептиды при рН=7,0 (нейтральная среда).
Решение:

ЗАДАНИЕ 8
Известно, что водородная связь – форма взаимодействия между более электроотрицательным атомом (например, N, O) и менее электроотрицательным атомом водорода H. Такие связи легко реализуются между молекулами воды, спиртов, между азотистыми основаниями в составе нуклеиновых кислот, а также в пептидах и белках.
Предположим, что биохимик-исследователь работает со смесью следующих аминокислот:
Фен, Асн, Лей, Ала, Глу, Лиз, Вал. Выберите среди них те аминокислоты, радикалы которых могут участвовать в образовании водородных связей в белках. Поясните свой ответ.
Решение:

ЗАДАНИЕ 9
В учебной лаборатории по биохимии на полке находятся следующие флаконы с органическими веществами:

Выпишите названия веществ, которые дают нижеследующие положительные качественные химические реакции:
А) Нингидриновая реакция: _______________________________________________
Б) Ксантопротеиновая реакция:____________________________________________
В) Реакция Фоля: _______________________________________________________
Г) Биуретовая реакция: __________________________________________________
Д) Реакция с нитратом серебра: ___________________________________________
ЗАДАНИЕ 10На занятии по биохимии студентам предложили проанализировать состав и свойства вещества под названием «Аспакам». Соединение имеет сладкий вкус и следующую химическую формулу.

Проанализируйте химическую структуру аспаркама, выделите в формуле те фрагменты, которые вам уже известны, подпишите их. Предположите область применения этого вещества.
Пояснение:
ЗАДАНИЕ 11На занятии по биохимии студентам предложили проанализировать состав и свойства пептида следующего строения:
Асп-Цис-Асн-Глн-Сер-Вал-Лиз-Цис-Гис-Гли-Лиз-Иле-Глу-Лей
Один из студентов предположил, что при взаимодействии между боковыми заместителями аминокислот в структуре пептида произойдет образование дисульфидных мостиков, ионных и гидрофобных связей. Чем подтвердить такое предположение? Выпишите пары аминокислот, между которыми действительно возможны такие взаимодействия.
Решение:
________________________________________
________________________________________
ЗАДАНИЕ 12
Дайте характеристику пары аминокислот, выбрав верные утверждения:


Дайте характеристику пары пептидов, заполнив колонку с ответами:

ЗАДАНИЕ 14
Допишите формулу тетрапептида, состоящего из протеиногенных аминокислот таким образом, чтобы полученный пептид соответствовал перечисленным характеристикам:
А. Тетрапептид заряжен положительно при нейтральном значении рН.
Б. Тетрапептид содержит ароматическую аминокислоту без гидроксильной группы.
В. Тетрапептид содержит аминокислоту, содержащую гуанидиновый фрагмент
Г. Тетрапептид содержит серосодержащую аминокислоту, которая дает положительную реакцию Фоля.

15.1. Составьте структурную формулу пентапептида следующего строения:
Цис-Арг-Фен-Глу-Трп
а) Обозначьте N- и С-концы пептида
б) Отметьте регулярно повторяющиеся фрагменты пептида (пептидные связи) и боковые заместители (радикалы) остатков аминокислот.
в) Какие из цветных реакций будут положительны с данным пептидом?
г) Определите суммарный заряд пептида при следующих условиях:
Z=? pH=7,0; Z=? pH=1,0; Z=? pH=12,0
Пояснение:
15.2. В медицине для профилактики и лечения заболеваний суставов используется запатентованный препарат, представляющий собой смесь химически модифицированных пептидов
Ala-Glu-Asp, Lys-Glu-Asp и Lys-Glu.
Данный препарат нормализует морфоструктуры суставных тканей, в том числе цитоархитектоники хрящевой ткани с уменьшением количества хондроцитов, подверженных апоптозу, особенно на конечных его стадиях. Составьте формулы указанных трипептидов. Рассчитайте их суммарный заряд при pH=7,0.

Пояснение:
15.3. В медицине в качестве противовоспалительного и анальгетического средства используется запатентованный препарат, представляющий собой химически модифицированный трипептид: Tyr-Pro-Ser. Составьте формулу указанного трипептида. Рассчитайте его суммарный заряд при pH=7,0; pH=2,0.; pH=12,0.

Пояснение:
ЗАДАНИЕ 16*На формуле тетрапептида обведите боковые заместители (радикалы) отдельных аминокислот, формирующих пептид, обозначьте N- и С-концы. Выделите пептидные связи. Назовите пептид с учетом того, что аминокислотные остатки пелечисляются от N-конца. Определите суммарный заряд данного тетрапептида при рН = 7,0 рН = 2,0 и рН = 12,0 и укажите направление его движения в электрическом поле (к катоду, к аноду, без движения).

ЗАДАНИЕ 17*
В биохимическую лабораторию направлена смесь из двух пептидов. У исследователей имеется все необходимое оборудование и реактивы для проведения качественного и количественного анализа веществ и их смесей. Установлено, что в составе анализируемой смеси есть пептид, который состоит из β-Ала и Гис, а также пептид, который имеет в составе Глу, Цис и Гли. Было сделано предположение о том, что пептиды, представленные на анализ, являются карнозином и глутатионом.
Составьте формулы предполагаемых пептидов. В чем особенность включения Глу в состав глутатиона? Предположите, какими методами анализа воспользовались биохимики при разделении смеси этих веществ и какие качественные химические реакции на отдельные аминокислоты в составе пептидов они провели. Дайте обоснование.
Решение:

В таблице представлены характеристики некоторых белков. Используя эти данные предположите методы разделения и анализа трех белков, находящихся в одной смеси:
лизоцим, гамма-глобулин и пепсин. Составьте план разделения. Дайте соответствующие пояснения.

Решение:
1. Особенности структуры и свойств выбранных соединений
2. Выбранные методы анализа
3. Обоснование метода
ЗАДАНИЕ 19*В таблице представлены характеристики некоторых белков. Используя эти данные предположите методы разделения и анализа трех белков-ферментов, находящихся в одной смеси: рибонуклеаза, лизоцим и ксантиноксидаза. Составьте план разделения. Дайте соответствующие пояснения.

Решение:
1. Особенности структуры и свойств выбранных соединений
2. Выбранные методы анализа
3. Обоснование метода
ЗАДАНИЕ 20*В таблице представлен аминокислотный состав некоторых белков. Используя эти данные предположите методы разделения и анализа трех белков, находящихся в одной смеси:
пепсин, альбумин, гистон. Составьте план разделения. Дайте соответствующие пояснения.

1. Особенности структуры и свойств выбранных соединений
2. Выбранные методы анализа
3. Обоснование метода
Раздел 3. Нуклеозиды и нуклеотиды. Нуклеиновые кислоты. Матричные биосинтезы

Составные части мононуклеотида (азотистое основание, сахар пентоза, фосфат)
Нуклеозид
Нуклеотид
Нуклеиновые кислоты
Денатурация ДНК
Нуклеопротеины
ДНК
РНК
Аденин
Гуанин
Цитозин
Тимин
Урацил
Рибоза
Дезоксирибоза
Репликация
Транскрипция
Трансляция
Иметь представление о/об (знать)О строении важнейших сложных белков (гемоглобин и миоглобин)
О характере связи между рибозой (дезоксирибозой) и азотистым основанием в нуклеозидах
О характере связи между мононуклеотидами в составе нуклеиновых кислот
Об уровнях структурной организации нуклеиновых кислот
О типах нуклеиновых кислот
Строении т-РНК, и-РНК, ДНК
О методах разделения и анализа нуклеиновых кислот
О принципах и условиях матричных биосинтезов
Уметь составлять формулынуклеозидов и нуклеотидов, анализировать их состав и заряд

Какой термин соответствует представленному понятию:
а) Соединение, в котором пуриновое или пиримидиновое основание связано с рибозой или дезоксирибозой – …
б) Группа органических соединений, у которых гидроксильный остаток пентозы в составе нуклеозида этерифицирован одной или несколькими фосфатными группами – …
в) Процесс, сворачивания полипептидной цепи в уникальную трехмерную пространственную структуру – …
г) Видоизмененные азотистые основания, отличающиеся по строению от аденина, гуанина, урацила и тимина – …
ЗАДАНИЕ 2На представленных рисунках найдите структуру, соответствующую пурину и структуру, соответствующую пиримидину. Какой из этих гетероциклов является конденсированным и состоит из двух частей – пиримидина и имидазола? Подпишите составные части гетероциклов.

Назовите известные вам природные соединения производные пиримидина и пурина.
ЗАДАНИЕ 3Известно, что чай и кофе содержат алкалоиды пуринового ряда. Проанализируйте формулы пуриновых алкалоидов. Выделите в этих формулах гетероциклическую часть.

В вашем распоряжении имеются формулы следующих веществ:

Используя представленные структурные компоненты, составьте химические формулы:
а) двух любых нуклеозидов
б) двух любых нуклеотидов
ЗАДАНИЕ 5Дайте характеристику двум соединениям, формулы которых приведены ниже:

а) Название первого соединения _____________
название второго __________________________
б) Общее число нуклеотидов на рисунке__
Общее число дезоксисахаров на рисунке__названия сахаров:
Общее число моль пуриновых соединений на рисунке __, из них аденина ___
б) Суммарный заряд первого соединения___
в) Число водородных связей, образуемых первым соединением в составе ДНК___
ЗАДАНИЕ 6Дайте характеристику двум соединениям, формулы которых приведены ниже:

а) Название первого соединения _____________
название второго __________________________
б) Число сложноэфирных связей в первом соединении__
Число моль рибозы двух соединении__
Число моль гуанина в двух соединениях __
б) Суммарный заряд первого соединения___
в) Число водородных связей, образуемых вторым соединением в составе ДНК___
ЗАДАНИЕ 74.1. Дайте название соединениям, формулы которых приведены ниже:______________________
Укажите, являются ли эти соединения:
□ нуклеотидом □ нуклеозидом □ азотистым основанием
Стрелками укажите на формулах N-гликозидную связь и сложноэфирную связи
Укажите на формулах атомы, которые образуют водородные связи с комплементарным азотистым основанием (обведите конкретные атомы).


Дайте характеристику двум соединениям, представленным выше, выбрав верные утверждения:

ЗАДАНИЕ 9

Дайте характеристику пары веществ, заполнив колонку с ответами:


Подпишите названия азотистых оснований, входящих в структуру:
Укажите, какое их них – пуриновое, а какое – пиримидиновое:
На рисунке выделите 3’,5’– фосфодиэфирную связь.
Может ли данное соединение быть фрагментом тРНК? Обоснуйте свой ответ.
Пояснение:
ЗАДАНИЕ 11В арсенале современных лекарственных средств используется препарат, формула которого представлена выше. Это средство зарегистрировано под торговым наименованием Кладрибин. Какие особенности структуры вы заметили у данного препарата? Предположите биологические свойства этого вещества.

Пояснение:
ЗАДАНИЕ 12В медицине используется препарат Инозин (рибоксин) как предшественник адениловых и гуаниловых нуклеотидов.

Что такое нуклеотиды? Опишите состав и биологическую роль аденозина и гуанозина в организме. Подпишите составные компоненты инозина. На основе структуры инозина объясните, почему это препарат является предшественником АТФ. Опишите предполагаемый механизм образования АТФ из инозина.
Пояснение:
ЗАДАНИЕ 13Перед вами представлена формула оротовой кислоты, калиевая соль которой используется в медицине под названием «Калия оротат». Это вещество является предшественником пиримидиновых азотистых оснований.

Как вы объясните причину использования данного препарата при ишемической болезни сердца?
Пояснение:
ЗАДАНИЕ 14Перед вами представлена формула основного компонента препарата «Изопринозин»

Это синтетическое комплексное производное пурина, обладающее иммуностимулирующей активностью и неспецифическим противовирусным действием.
Какие химические компоненты входят в состав данной структуры? Как вы объясните противовирусный эффект данного вещества?
Пояснение:
ЗАДАНИЕ 15*Аналоги нуклеозидов – это группа лекарственных средств, проявляющих активность в отношении генома вирусов, поскольку они предотвращают репликацию вируса в инфицированных клетках. Наиболее часто используется препарат Ацикловир. Как вы объясните механизм действия такого препарата основе его химической структуры? Предположите механизм действия ацикловира.

Пояснение:
ЗАДАНИЕ 16
Пояснение:
ЗАДАНИЕ 17
Пояснение:
ЗАДАНИЕ 18Ниже представлены две последовательности мРНК:
5’ ЦУУЦЦУААУАГУАГАГУЦ 3’
5’ ЦУЦЦЦАААЦАГЦАГГГУА 3
а) Запишите аминокислотные последовательности, закодированные в данных фрагментах мРНК;
б) Запишите структурную формулу второй аминокислоты в структуре первого пептида.

Таблица «Генетический код»

Фрагмент смысловой цепи ДНК имеет следующую нуклеотидную последовательность: 5’АТТГЦЦЦАТАТГГТАТГА 3’
а) Запишите вторую цепь ДНК.
Запишите последовательность нуклеотидов мРНК, синтезируемой на данном фрагменте молекулы ДНК
б) Какая аминокислота закодирована третьим кодоном? Запишите ее структурную формулу и укажите ее классификацию по характеру бокового заместителя?

ЗАДАНИЕ 20
Фрагмент кодирующей (смысловой) цепи ДНК имеет следующую последовательность нуклеотидов: 5 ГЦАЦААТТГАГГЦЦЦАГТТААГТА 3.
а) Напишите полную аминокислотную последовательность, которая закодирована в указанном фрагменте ДНК
б) Какая аминокислота закодирована четвертым кодоном в структуре м-РНК? Запишите ее структурную формулу и дайте ее классификацию по характеру бокового заместителя?

ЗАДАНИЕ 21
Исследователь биохимической лаборатории выделил следующий фрагмент молекулы мРНК:
5 ГЦГАУУГГГЦГААААЦЦГ 3
а) Запишите аминокислотные последовательности, закодированные в данных фрагментах мРНК;
Запишите антисмысловую (транскрибируемую) и смысловую (кодирующую) цепи ДНК.
б) Какой суммарный заряд имеет этот пептид при рН 7,2, 2,3 и 12,5
Пояснение:
Раздел 4. Сложные белки

Простые белки
Сложные (конъюгированные белки)
Гем
Флавины
Гемоглобин
Миоглобин
Молекулярная масса
Амфотерность
Растворимость
Онкотическое давление
Лиганд
Сродство к лиганду
ЗнатьКлассификацию и особенности строения сложных белков
Примеры сложных белков в каждой группе
Фосфопротеины: определение, функции, выполняемые в биосистемах
Липопротеины: определение, функции, выполняемые в биосистемах
Хромопротеины: определение, функции, выполняемые в биосистемах
Нуклеопротеины: определение, функции, выполняемые в биосистемах
Металлопротеины: определение, функции, выполняемые в биосистемах
Гликопротеины: определение, функции, выполняемые в биосистемах
Серповидно-клеточную анемию
Талассемии
Уметь анализировать формулыГема
Миоглобина
Гемоглобина

Заполните недостающие фрагменты таблицы «Металлопротеины», иллюстрирующей состав и функции сложных белков.

На рисунке представлена схема строения сложного белка – гемоглобина взрослого человека (HbA).
Покажите, как выглядит график зависимости насыщения кислородом этого белка.
Подпишите оси X (степень насыщения белка кислородом, %), Y (Парциальное давление газа, мм рт. ст).

В той же системе координат покажите зависимость насыщения кислородом двух сложных белков – миоглобина (Mb), фетального гемоглобина (HbF). Какова способность всех трех белков к насыщению кислородом?
ЗАДАНИЕ 3На рисунке представлены графики зависимости насыщения гемоглобина кислородом в разных условиях.

На графике укажите кривую, соответствующую кривой насыщения гемоглобина кислородом при уменьшении концентрации CO2. Объясните ответ.
Объясните эффект Бора в связывания гемоглобина с кислородом.
На графике укажите кривую, соответствующую кривой насыщения гемоглобина кислородом в отсутствии 2,3-бисфосфоглицерата. Объясните ответ.
Опишите биологическую роль 2,3-бисфосфоглицерата в регуляции связывания гемоглобина с кислородом.
ЗАДАНИЕ 4Сила, с которой кислород связывается с гемоглобином, зависит сразу от нескольких факторов. Эти факторы сдвигают или изменяют форму кривой диссоциации оксигемоглобина. Сдвиг вправо указывает на то, что исследуемый гемоглобин имеет пониженное сродство к кислороду. Это затрудняет связывание гемоглобина с кислородом (для достижения того же насыщения кислородом требуется более высокое парциальное давление кислорода), но облегчает выделение гемоглобином связанного с ним кислорода.
Заполните недостающие параметры в таблице, описывающей графики зависимости насыщения гемоглобина кислородом в разных условиях.

Пояснение:
ЗАДАНИЕ 5Серповидноклеточная анемия (рисунок картины крови ниже) – наследственная гемоглобинопатия, связанная с таким нарушением строения белка гемоглобина, при котором он приобретает особое кристаллическое строение. Форма гемоглобина больных – так называемый гемоглобин S.
Каковы биологические и физико-химические свойства гемоглобина в норме и что меняется при патологии? Дайте объяснение на основе схемы ниже:

Пояснение:
ЗАДАНИЕ 6Талассемия (рисунок картины крови ниже) – генетическое заболевание, возникает при повреждении генов гемоглобина и тяжесть заболевания зависит от глубины поломки генов. При талассемии наблюдаются характерные изменения в клиническом анализе крови. Резко снижены количество эритроцитов, уровень гемоглобина (при тяжелых формах – иногда до 20–30 г/л) и цветовой показатель. Эритроциты крови уменьшенного размера, зачастую необычного вида – так называемые «мишеневидные».
Какова структура глобиновых цепей гемоглобина в норме? Опишите их.
На рисунке подпишите составные части гемоглобина:

В таблице представлены характеристики трёх белков.

В чем вы видите отличия между ними? Предложите методы, которые можно использовать для разделения этих белков. Дайте обоснование своему выбору.
Опишите особенности структуры и биологические функции каждого из представленных белков.
Решение:
ЗАДАНИЕ 8Подпишите составные части гема. Найдите структуры пиррола, метиленовые мостики и остатки пропионовой кислоты.

Что является полярной частью молекулы?
Какова роль железа в этой структуре?
Назовите гемовые белки в организме человека.
ЗАДАНИЕ 9Известно, что к металлопорфиринам относятся ферменты, принадлежащие к семейству цитохромов Р-450 (рис. ниже). Эти ферменты и существует в различных биообъектах (в растениях, бактериях и млекопитающих). Ферменты Р-450 играют ключевую роль в окислительной трансформации эндогенных и экзогенных молекул, а их активный центр содержит протопорфирин железа(III)-IX, ковалентно связанный с белком атомом серы проксимального цистеинового лиганда.

